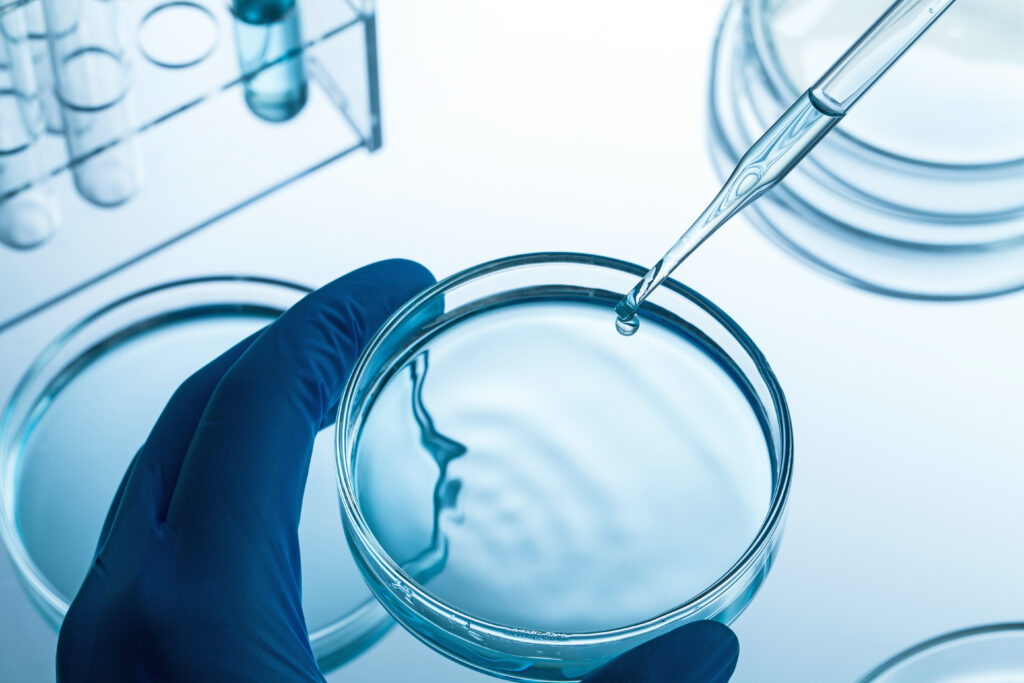

遺伝毒性試験として、AMES(エームス)試験や小核試験等の言葉は知っているが一体それがどんな試験なのか、そもそも遺伝毒性とはなんなのか、今更聞けない内容について基礎からわかりやすく説明いたします。
遺伝子とは
DNAという文字で書かれ生物の「設計図」を指し、
さらにそれが、染色体という「本」にまとめられています。
ヒトの染色体は46本(23本×2セット) 、
即ち両親から23巻セットの設計図を1セットずつ受け継いでいます。
遺伝毒性とは
| 変異(突然変異) | 設計図に誤りが生じる現象 |
| 変異原性または遺伝毒性 | 設計図に誤りを生じさせる作用 |
遺伝毒性の種類
DNA損傷
「設計図」の文字が消える、穴があく等
遺伝子突然変異
「設計図」の文字が置き換わる等により、言葉や文章の意味が変わる
染色体異常
「本」のページ・章が消える
ページ・章が余分に増える
ページ・章の順番が変わる
1冊まるごと消える、増える等
DNA損傷と遺伝子突然変異の違い
- 正しい指示 「水を100L入れる」
誤った指示「水を100L入れた」 →DNA損傷あり、遺伝子突然変異なし(製品に影響なし)
誤った指示「水を10L入れる」
誤った指示「油を100L入れる」 →DNA損傷あり、遺伝子突然変異あり(製品に影響あり)
遺伝毒性試験の種類
変異で生じた傷などを直接または間接的に測定する方法
- 染色体異常試験
- 小核試験
- コメットアッセイ など
変異した細胞(菌)の性質が変化するのを利用して、変異細胞(菌)の増減を指標に測定する方法
- AMES試験(復帰突然変異性試験)
- マウスリンファーマ試験(MLA)
- トランスジェニック動物試験 など
お問い合わせ
上記試験ならびにその他試験も取り揃えております。
化粧品に関する評価試験についてご興味がございましたら、こちらからお問合せください。












